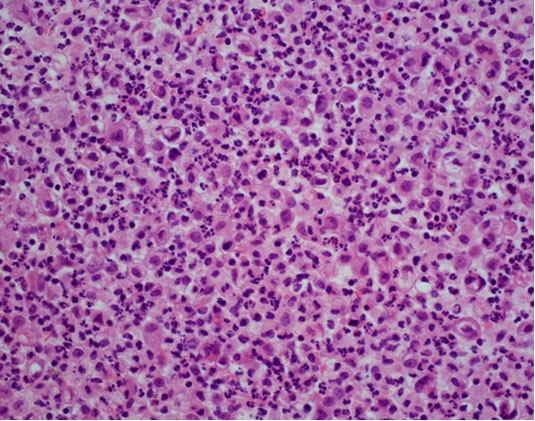

|
Case Report
A rare presentation of malignant peritoneal mesothelioma in a 22-year-old man
1 Department of Medicine, Einstein Medical Center, Philadelphia, PA, USA
2 Division of Gastroenterology and Hepatology at Einstein Medical Center, Philadelphia, PA, USA
Address correspondence to:
Simone A Jarrett
Internal Medicine, Einstein Medical Center, Philadelphia, 5501 Old York Road, Philadelphia, Pennsylvania 19141,
USA
Message to Corresponding Author
Article ID: 100101Z10SJ2022
Access full text article on other devices

Access PDF of article on other devices

How to cite this article
Jarrett SA, Chiang B, Hiedra R, Kalman RS. A rare presentation of malignant peritoneal mesothelioma in a 22-year-old man. J Case Rep Images Oncology 2022;8:100101Z10SJ2022.ABSTRACT
Introduction: Peritoneal mesothelioma is a rare malignancy. The etiology is unclear but a majority of cases are associated with asbestos exposure and heavy metal exposure. There is also no standardized management for this disease.
Case Report: This is a 22-year-old man who presented with ascites with no history of asbestosis or heavy metal exposure. He had a computed tomography (CT) scan completed that showed extensive metastatic disease involving lymph nodes above and below the diaphragm, peritoneal carcinomatosis, and large bilateral pleural effusions. An omental node biopsy confirmed the diagnosis of primary malignant peritoneal mesothelioma (MPM). He was started on a palliative chemotherapy regimen, extrapolated from pleural mesothelioma treatment, which consisted of cisplatin and pemetrexed.
Conclusion: Further research into possible risk factors and exposures that cause MPM, as well as forming standardized treatment is needed to improve prognosis and management of these patients.
Keywords: Ascites, Cancer, Mesothelioma, Oncology, Rare, Young adult
Introduction
Primary peritoneal mesothelioma is a rare and aggressive malignancy that arises from mesothelial cells in the peritoneum. The majority of cases are related to asbestos exposure but there are also nonasbestos etiologies [1]. The peritoneum is the second most common site after pleural mesothelioma. Patients usually present with nonspecific symptoms of fatigue, malaise, abdominal distension, abdominal pain leading to a delayed diagnosis. When diagnosed, most patients are in the end stage of disease and have a poor medical prognosis. The median survival rate is 10 months and the relative 5-year survival rate is 10% [2]. The treatment for primary peritoneal mesothelioma is not standardized and guidelines are not well defined, creating another obstacle toward optimizing management.
Case Report
A 22-year-old Caucasian man with a history of antiphospholipid syndrome, pulmonary embolism maintained on warfarin presented with complaints of ascites. The patient had been previously healthy until he began to have abdominal distension at age 13 which required paracentesis on two separate occasions. Subsequent to this he had remained in good health. Laboratory and imaging investigations during that time were unrevealing with no evidence of cirrhosis, heart or kidney disease and no etiology for his ascites was determined. He had no prior history of sick contacts, incarceration, intravenous drug abuse, or travel to tuberculosis endemic countries. His family history was also noncontributory. On physical examination in the emergency room he was hypoxic to 90% on room air, tachycardic to 115, and afebrile with a normal blood pressure. He appeared cachectic and diaphoretic with decreased bilateral breath sounds and non-tender abdominal distension. There was no lymphadenopathy or other stigmata of liver disease.
The patient’s basic laboratory investigations revealed hyponatremia to 123, normocytic anemia with hemoglobin of 12.4, leukocytosis with neutrophilia (37.46 × 103/mcL), and thrombocytosis (689 × 103/mcL) with normal transaminases but elevated alkaline phosphatase levels at 321 IU/L. Complement levels were within normal limits. Chest X-ray revealed bilateral pleural effusions with compressive atelectasis and pulmonary edema. Computed tomography (CT) imaging of the abdomen and pelvis (Figure 1A and Figure 1B) revealed extensive metastatic disease involving lymph nodes above and below the diaphragm as well as peritoneal carcinomatosis, large bilateral pleural effusions, pulmonary hypertension, and splenic infarcts. Further lab workup including Acute Hepatitis Panel A, B, and C antibodies, QuantiFERON Gold, HIV, anti-Ro, anti-smooth muscle, and anti-nuclear antibody were negative however his anti-double stranded DNA and anticardiolipin were positive. Paracentesis done at the bedside showed yellow, opaque, chylous fluid with high serum albumin ascites gradient and elevated white blood cell count at 16,000 with neutrophils of 45%, triglycerides of 380 and multiple mesothelial cells. Findings were consistent with chylous ascites and possible primary peritonitis for which he received intravenous ceftriaxone. He underwent scrotal ultrasound which showed no evidence of testicular malignancy as well as esophagogastroduodenoscopy which was unremarkable.
The patient was admitted to the hepatology inpatient service with consults from rheumatology, infectious disease, hematology, nephrology, pulmonology, and interventional radiology for a multidisciplinary approach to management. He underwent paracentesis followed by thoracentesis and an ultrasound guided peritoneal nodule biopsy. Turbid white chylous fluid (1200 mL) was removed from the left chest. The initial clinical impression from pulmonary was that the bilateral chylous effusion was likely secondary to superior vena cava syndrome and left brachiocephalic obstruction caused by lymphadenopathy. He was commenced on a low cholesterol diet and nutrition was consulted. Laboratory results from the first peritoneal tap showed atypical mesothelial cells indeterminate for malignancy (Figure 2). Subsequent thoracentesis (Figure 3) and paracentesis (Figure 4) specimens had higher cellular yield and revealed highly atypical mesothelial cells with high nuclear to cytoplasmic ratios and prominent nucleoli suggestive of malignant mesothelioma. Tumor cells were immunoreactive with Calretinin immunohistochemistry stain (Figure 5) which supported mesothelial origin rather than an epithelial origin (carcinoma). The diagnosis was further confirmed by an ultrasound guided peritoneal nodule biopsy which showed a consolidation of epithelioid tumor cells consistent with malignant mesothelioma, epithelioid type (Figure 6). Immunohistochemical staining of the omental biopsy for Ki 67 staining showed a high proliferative index > 10% (Figure 7). The tumor also contained foci of inflammatory cells including many plasma cells. These inflammatory cells could be reactive to the tumor or related to an underlying autoimmune or inflammatory process.
The patient was diagnosed with primary peritoneal mesothelioma with metastatic disease presenting as recurrent ascites. His condition was explained in detail, including his prognosis and limited treatment options due to the fact that there were no standard National Comprehensive Cancer Network (NCCN) guidelines nor staging for primary peritoneal mesothelioma. The patient opted for palliative chemotherapy. His treatment regimen of cisplatin/pemetrexed was extrapolated from treatment for primary pleural mesothelioma as well as best supportive care. Unfortunately, the patient died six months after his diagnosis.
Discussion
This patient was a rare and unusual case of a young male presenting as recurrent episodes of isolated ascites for approximately 10 years resulting in an ultimate diagnosis of malignant peritoneal mesothelioma. Malignant mesothelioma is a very rare neoplasm seen commonly in elderly patients that can arise from the mesothelial surfaces of the pleural cavity, peritoneal cavity, tunica vaginalis, or pericardium. The most common type of mesothelioma is malignant pleural mesothelioma and its incidence is rising worldwide. Malignant peritoneal mesothelioma (MPM) represents only one-fourth of all cases of mesothelioma, however, remains as the second most common type of mesothelioma [3].
The pathogenesis of mesothelioma is strongly linked with industrial pollutants and mineral exposure of which asbestos is the principal carcinogen associated with disease. However, while asbestos is the best-defined risk factor for MPM, the association is weaker compared to the asbestos association with pleural mesothelioma as only 33–50% of patients diagnosed with MPM report any known prior exposure to asbestos [4]. Cases have also been reported following exposure to erionite and Thorotrast, providing further evidence of common etiological factors with the pleural form of the disease. The role of other suspected risk factors, such as recurrent peritonitis, simian virus 40 infection, and genetic predisposition such as germline BRCA-associated protein 1 (BAP1) mutation, is unclear at present [1],[5]. The epidemiology of peritoneal mesothelioma is complicated with incidence rates in industrialized countries ranging between 0.5 and 3 cases per million in men and between 0.2 and 2 cases per million in women however this may be inaccurate due to possible geographic and temporal variations in diagnostic practices [1].
The vast majority of patients, as in our case, typically present with worsening abdominal distension, abdominal pain, abdominal or pelvic masses, thrombocytosis, thromboembolic events as well as nonspecific signs and symptoms such as fever, unintentional weight loss, fatigue, malaise, and other constitutional symptoms. Lymphadenopathy or distant organ metastasis is extremely rare in this disease. Five percent of patients may also present with concomitant pleural effusion as is the case with our patient [3]. Imaging findings show equally well on CT and magnetic resonance imaging (MRI) with usually diffuse and widespread involvement of the peritoneal cavity with tumor infiltration and irregular/nodular thickening of the peritoneum. None of the radiographic findings are sufficiently specific for MPM and there are no tumor markers sensitive or specific enough for diagnosis. However, similar to ovarian cancer Serum CA-125 may be elevated [3]. Tissue biopsy is usually required with immunohistochemical staining for confirmatory diagnosis.
There is no uniformly accepted staging system for MPM and morbidity and mortality remains extremely high due to progression of peritoneal invasion. For selected patients with diffuse disease, no extraperitoneal disease spread, good performance status, and have predicted achievement of complete surgical cytoreduction, regional therapy using cytoreduction surgery (CRS) and hyperthermic intraoperative peritoneal perfusion with chemotherapy (HIPEC) are adopted as the therapeutic management [6]. Recent studies have shown that 6 patients following this treatment protocol have demonstrated long-term benefit up to 19 years post-treatment and favorable pharmacology which suggests the need for further study into this treatment option for those patients who present early [7]. However for patients such as ours pemetrexed plus cisplatin is an active regimen that is commonly used particularly in the palliative setting where performance status is poor.
While our patient had no risk factors for mesothelioma such as exposure to heavy metals and minerals, his presentation with ascites without a clear etiology despite extensive workup is important to note. Biopsy results from his omental tissue showed evidence of chronic inflammatory cells with plasma cells which could indicate that he had an underlying connective tissue disease or autoimmune process prior to the differentiation of benign neoplastic mesothelial proliferation to malignancy. In the literature there have been similar cases such as that described by Brown et al. (1968) of a patient who developed malignant mesothelioma of the peritoneum after 12 years of repeated induction of pneumoperitoneum for abdominal tuberculosis and Riddel et al. (1981) who described recurrent peritonitis due to diverticulitis leading to peritoneal irritation and subsequent development of mesothelioma [5],[8]. In our patient while the exact relationship between his chronic recurrent ascites and mesothelioma is unclear, in view of the time period and his young age of 22 with no prior risk factors, it is difficult to conclude that there is no relationship between the two diseases. For ten years the patient had ascites and such chronic irritation may have played a part in the pathogenesis of his final disease.
Conclusion
Malignant peritoneal mesothelioma has previously been reported on few occasions in the literature; however, to our knowledge, it has not been reported thus far in a patient this young without risk factors or exposures. Moreover, our case highlights the limited treatment modalities and the need for further research in this area for better management of these patients. Despite these limitations, control of exposure to asbestos, at the workplace, remains the main approach for the prevention of peritoneal mesothelioma.
REFERENCES
1.
Boffetta P. Epidemiology of peritoneal mesothelioma: A review. Ann Oncol 2007;18(6):985–90. [CrossRef]
[Pubmed]

2.
Howlader N, Noone AM, Krapcho M, et al. editors. SEER Cancer Statistics Review, 1975–2017. Bethesda: National Cancer Institute; 2020. [Available at: https://seer.cancer.gov/archive/csr/1975_2017/]

3.
Munkholm-Larsen S, Cao CQ, Yan TD. Malignant peritoneal mesothelioma. World J Gastrointest Surg 2009;1(1):38–48. [CrossRef]
[Pubmed]

4.
Bridda A, Padoan I, Mencarelli R, Frego M. Peritoneal mesothelioma: A review. MedGenMed 2007;9(2):32.
[Pubmed]

5.
Riddell RH, Goodman MJ, Moossa AR. Peritoneal malignant mesothelioma in a patient with recurrent peritonitis. Cancer 1981;48(1):134–9. [CrossRef]
[Pubmed]

6.
Yan TD, Deraco M, Baratti D, et al. Cytoreductive surgery and hyperthermic intraperitoneal chemotherapy for malignant peritoneal mesothelioma: Multi-institutional experience. J Clin Oncol 2009;27(36):6237–42. [CrossRef]
[Pubmed]

7.
Sugarbaker PH, Stuart OA. Unusually favorable outcome of 6 consecutive patients with diffuse malignant peritoneal mesothelioma treated with repeated doses of intraperitoneal paclitaxel: A case series. Surg Oncol 2020;33:96–9. [CrossRef]
[Pubmed]

8.
Brown JW, Kristensen KA, Monroe LS. Peritoneal mesothelioma following pneumoperitoneum maintained for twelve years. Report of a case. Am J Dig Dis 1968;13(9):830–5. [CrossRef]
[Pubmed]

SUPPORTING INFORMATION
Author Contributions
Simone A Jarrett - Conception of the work, Design of the work, Acquisition of data, Analysis of data, Drafting the work, Revising the work critically for important intellectual content, Final approval of the version to be published, Agree to be accountable for all aspects of the work in ensuring that questions related to the accuracy or integrity of any part of the work are appropriately investigated and resolved.
Brenda Chiang - Acquisition of data, Drafting the work, Revising the work critically for important intellectual content, Final approval of the version to be published, Agree to be accountable for all aspects of the work in ensuring that questions related to the accuracy or integrity of any part of the work are appropriately investigated and resolved.
Raul Hiedra - Conception of the work, Design of the work, Revising the work critically for important intellectual content, Final approval of the version to be published, Agree to be accountable for all aspects of the work in ensuring that questions related to the accuracy or integrity of any part of the work are appropriately investigated and resolved.
Richard S Kalman - Analysis of data, Revising the work critically for important intellectual content, Final approval of the version to be published, Agree to be accountable for all aspects of the work in ensuring that questions related to the accuracy or integrity of any part of the work are appropriately investigated and resolved.
Guaranter of SubmissionThe corresponding author is the guarantor of submission.
Source of SupportNone
Consent StatementWritten informed consent was obtained from the patient for publication of this article.
Data AvailabilityAll relevant data are within the paper and its Supporting Information files.
Conflict of InterestAuthors declare no conflict of interest.
Copyright© 2022 Simone A Jarrett et al. This article is distributed under the terms of Creative Commons Attribution License which permits unrestricted use, distribution and reproduction in any medium provided the original author(s) and original publisher are properly credited. Please see the copyright policy on the journal website for more information.